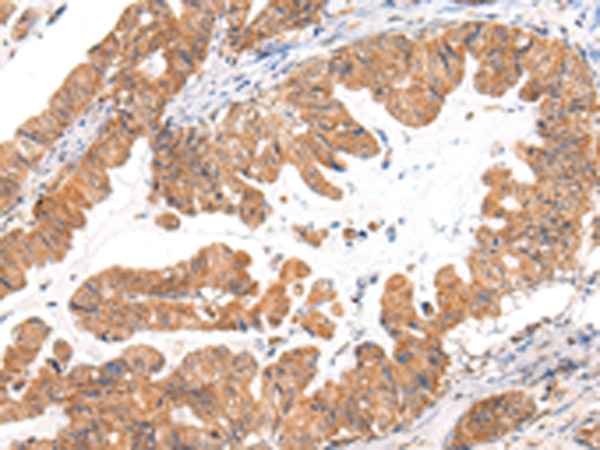

CASZ1 Antibody (aa1574-1601)
LS-C168337
ApplicationsWestern Blot
Product group Antibodies
TargetCASZ1
Overview
- SupplierLifeSpan BioSciences
- Product NameCASZ1 Antibody (aa1574-1601)
- Delivery Days Customer23
- ApplicationsWestern Blot
- Applications SupplierWB (1:1000)
- CertificationResearch Use Only
- ClonalityPolyclonal
- ConjugateUnconjugated
- Estimated Purity...
- Gene ID54897
- Target nameCASZ1
- Target descriptioncastor zinc finger 1
- Target synonymsCAS11; castor homolog 1, zinc finger; castor-related protein; CST; dJ734G22.1; SRG; survival-related; zinc finger protein 693; zinc finger protein castor homolog 1; ZNF693
- HostRabbit
- Storage Instruction-20°C,2°C to 8°C
- UNSPSC12352203